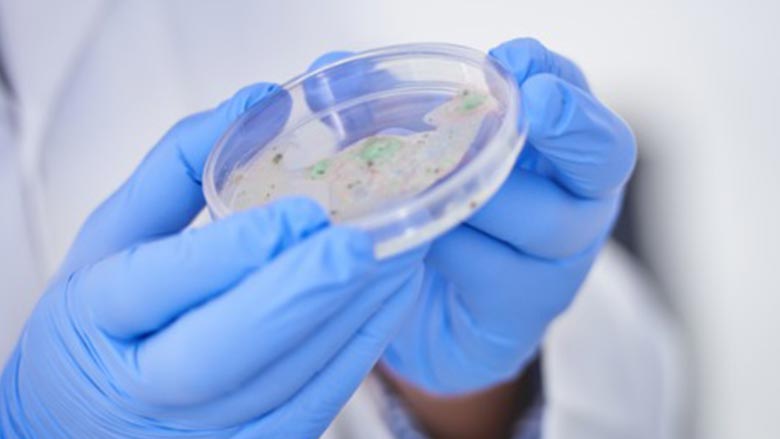

全國各地與狗糧和狗零食有關的沙門氏菌病例,引發加拿大公共衛生署 (PHAC) 的警告。
亞省報告病例最多,達13宗。卑詩省報告病例12宗,安省和西北地區各報告病例1宗。
加拿大公共衛生署的數據顯示,已有六宗沙門氏菌感染相關住院病例。該機構週一 (15日) 表示,目前尚無死亡病例。
衛生機構要求民眾在處理狗糧時保持良好的衛生習慣。
公共衛生署在聲明中表示,接觸狗隻、狗的食物或零食可能會感染沙門氏菌。即使狗隻沒有任何患病跡象,牠們仍然可能感染與其接觸或接觸環境的人。

為了降低感染風險,民眾在處理任何類型的狗糧或狗零食後,請務必立即用皂液和水徹底洗手;再次使用前,請清洗並消毒與狗糧接觸過的容器、用具和表面;為狗隻使用專用的碗碟和餐具,並將它們與其他碗碟分開清洗;
Advertisement
將狗糧和零食存放在遠離人類食物存放或製作的地方,並遠離兒童接觸的地方。
寵物吃完後,請將食物和零食容器帶走;遵循狗糧包裝上的儲存說明;閱讀狗糧包裝上的標籤,記下食材、有效期限,以及食物的生熟程度;以及接觸狗隻和處理其排泄物後,請洗手。
感染沙門氏菌的人即使沒有症狀,也可能在感染幾天到幾週後將病毒傳播給其他人。長者、幼兒、孕婦,以及免疫系統較弱的人罹患重病的風險較高。
沙門氏菌感染的症狀包括發冷、發燒、反胃、腹瀉、嘔吐、胃痙攣和突發性頭痛。大多數症狀會在四到七天內消失。
27 宗實驗室確診病例發生於今年 2 月中旬至 8 月中旬。約 59% 的感染者為女性。許多患病者報告稱,他們在生病前接觸過狗糧和零食。
目前尚未確定單一的狗糧供應商。加拿大公共衛生署稱,由於許多人症狀輕微且未就醫,本國實際患病人數可能更高。
研究人員估計,每報告一宗沙門氏菌病例,就有 26 宗未通報。
資料來源: 加拿大中文電台 FM94.7



















